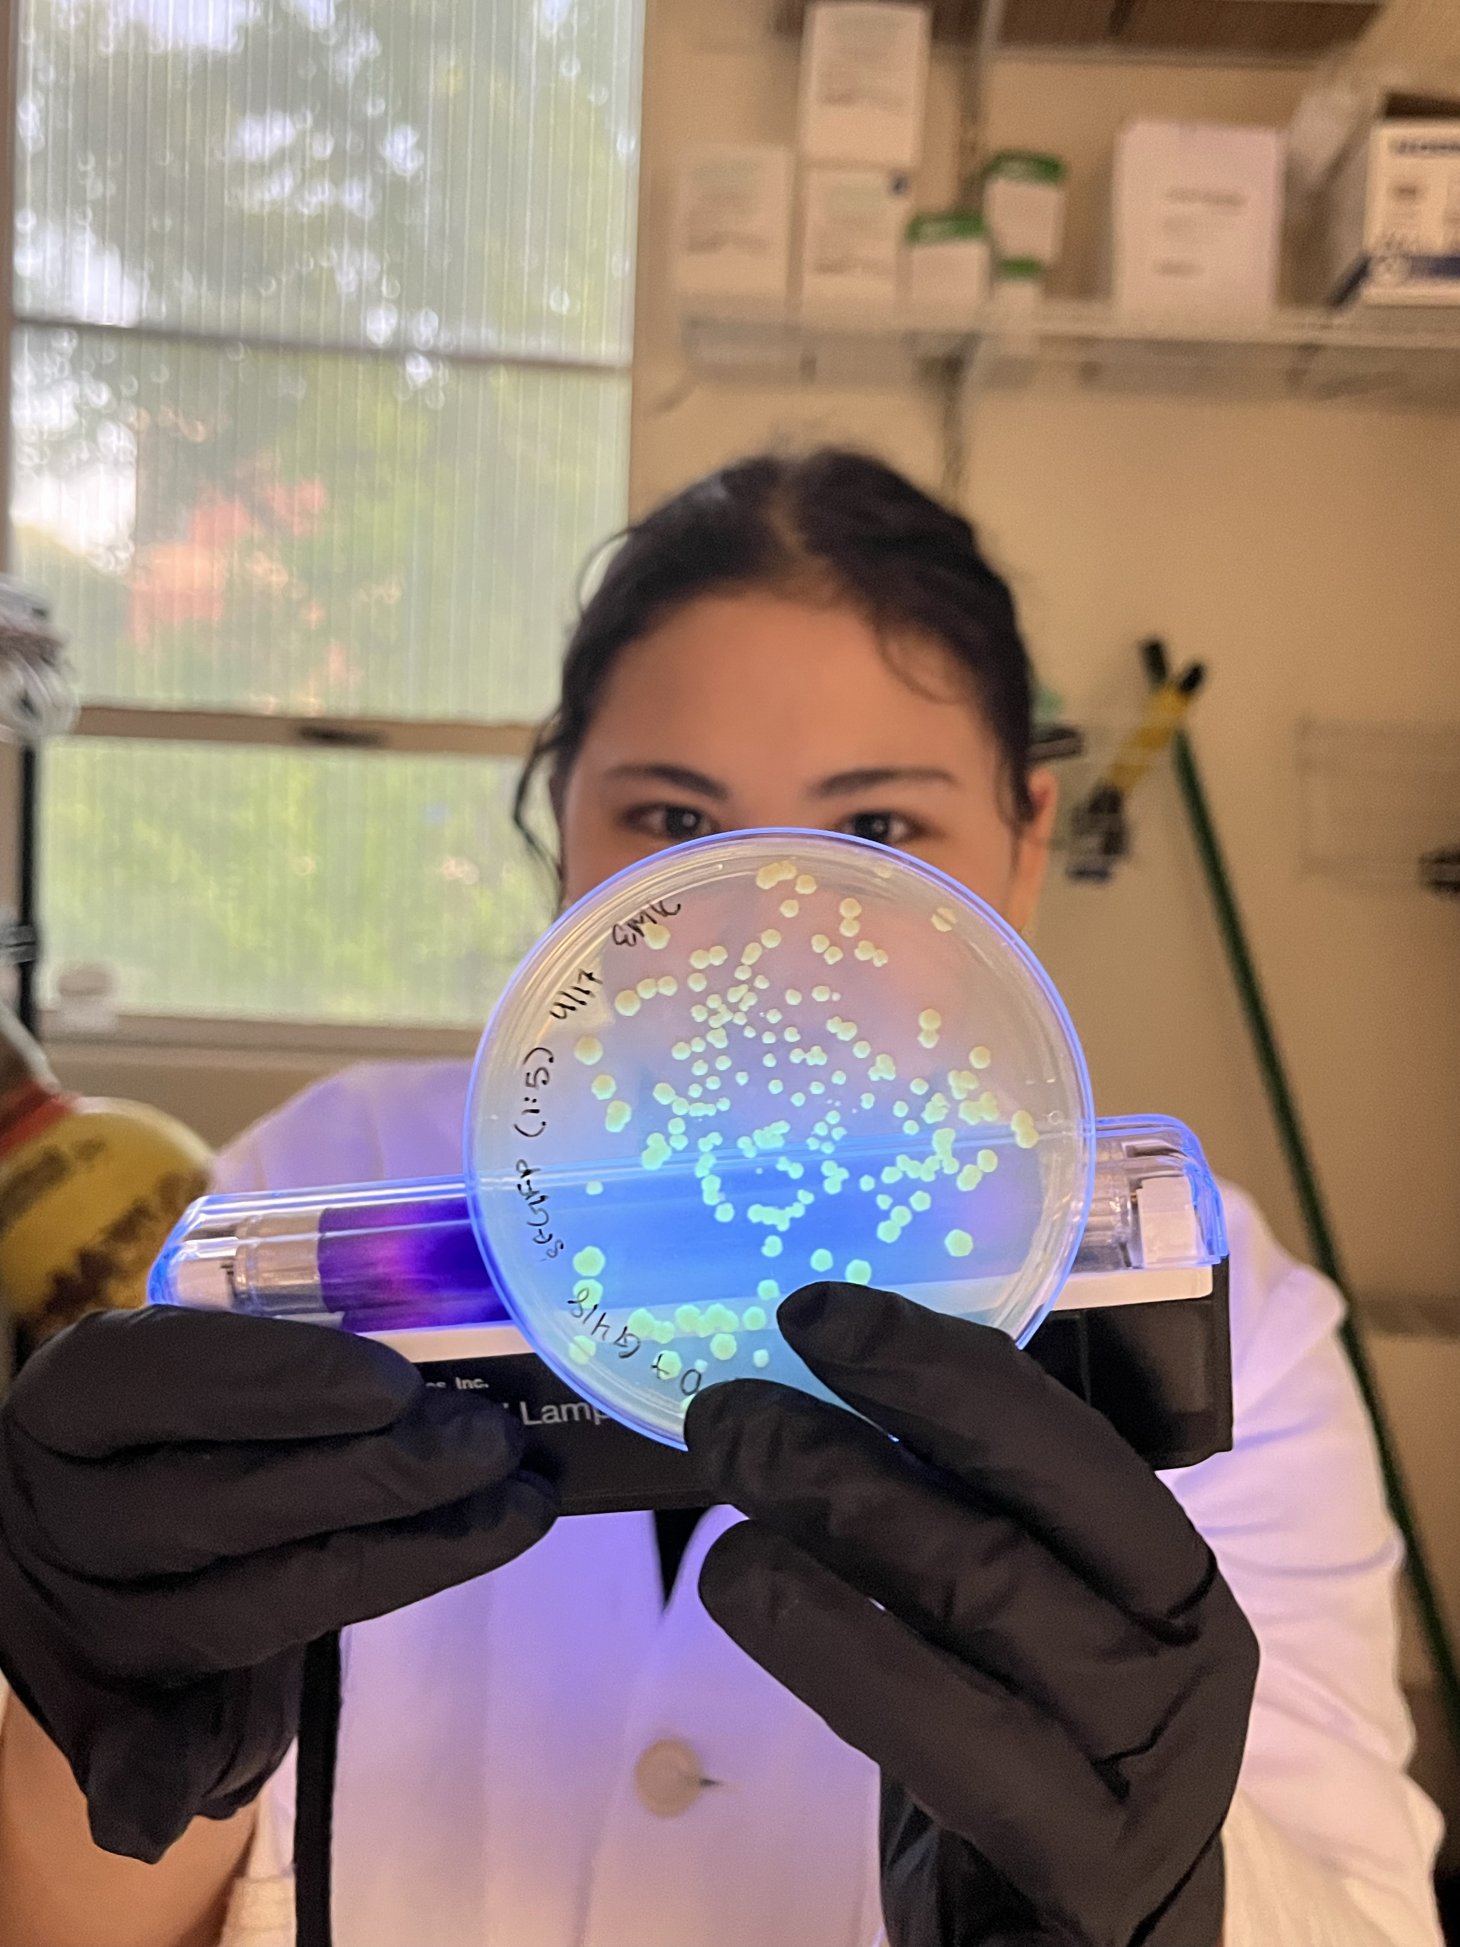
Kaneshiro shows green yeast in a petri dish using a backlight.

Wine science changed Emily Kaneshiro’s life. From riding bikes in the Netherlands to landing a summer internship at a small, family-owned winery in France’s Loire Valley, she fell in love with fermentation science. Specifically, the secrets behind what makes grapes the tastiest morsels of joy on the planet.
Now a senior majoring in biochemistry and molecular biology, Kaneshiro works in a paid position at the Curtin Lab on an independent research project to mitigate wildfire smoke taint in wine. Grapes absorb smoke like a sponge, and the resulting smoke flavor in the wine isn’t appealing.
Under the mentorship of Christopher Curtin, she hopes to solve this problem. After inserting genes into yeast and adding it to the wine, a pathway is introduced that allows smoke degradation to be possible. If successful, people could still relax with their friends and enjoy a glass of wine without the undesirable flavor.
“I think being able to get that support I've received, whether that's from parents, peers, friends or professors, has been vital to my success."
After she graduates this spring, she’s enrolling in the Vinifera Euromaster, a coalition of renowned wine science schools throughout Europe. But for now, she’s happy working in the lab at Oregon State.
“Getting experience in a lab will really let you know where you want to work. It gives you a lot of skills and more understanding of what working as a scientist really is,” she said. “I think it was really instrumental for me when choosing my career path.”